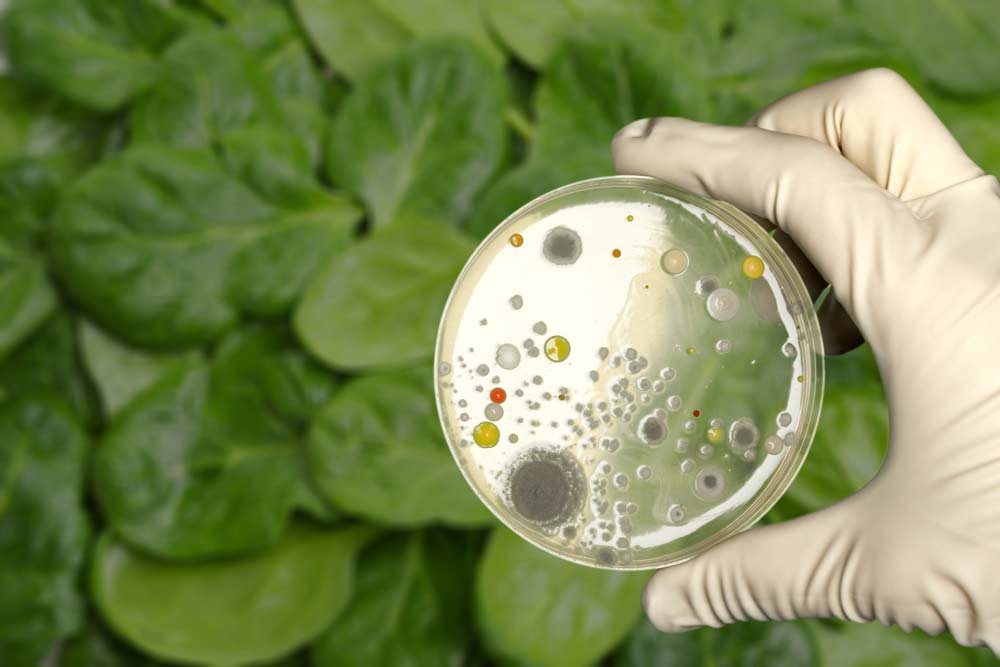
Естественная питательная среда
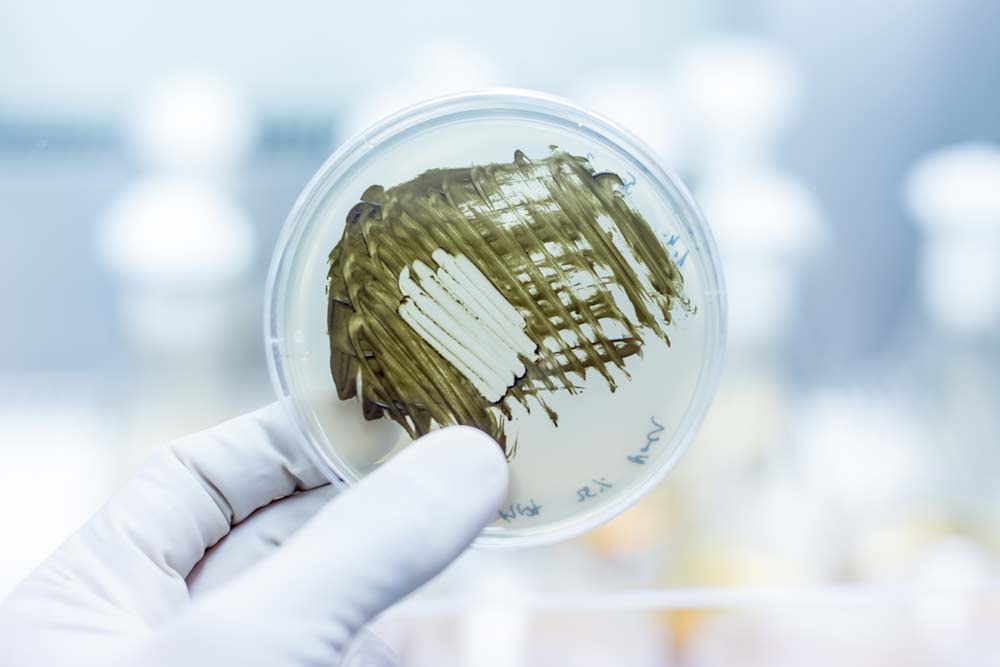
Консервирующие среды

Микробиологические среды — где используются, виды и назначение
- Главная страница
- Пресс-центр
- Статьи
- Микробиологические среды — где используются, виды и назначение
Для проведения различных исследований, отбора проб и культивирования микроорганизмов в микробиологии используются специальные питательные субстраты. Они могут различаться по происхождению, консистенции, составу и назначению. Что такое микробиологические среды, виды и назначение, сферы применения и другие особенности рассмотрим в этой статье.
Что такое микробиологические среды
Микробиологические или питательные среды — это вещество или смесь веществ, применяемых для исследований в сфере микробиологии (отбора проб, изучения свойств, выращивания микроорганизмов и пр.), которые соответствуют ряду определённых требований.
Они должны быть изотоничными, полностью стерильными, прозрачными, с оптимальным составом и оптимальным значением pH. Характеристики и свойства составов, как правило, максимально приближены к естественным для бактерий условиям. От качества субстратов зависит информативность и точность исследований.

Область применения
Область применения питательных сред достаточно широка — они применяются в биологии, медицине, сельском хозяйстве, фармацевтической промышленности, пищевом производстве, криминалистике.
Например, в медицине субстраты необходимы для диагностики различных инфекционных заболеваний, в фармацевтике — для получения вакцин, контроля стерильности лекарственных препаратов, в биологии — для культивирования биологических культур с целью более подробного их изучения. Среды обеспечивают бактериям осуществление всех жизненных процессов — питание, дыхание, размножение.

Классификация
Питательные составы различаются по нескольким критериям — способу происхождения, назначению, консистенции. Способ получения является одним из основных критериев — он делит все существующие субстраты на две большие категории. А именно:
Естественные
Естественные составы производятся из натуральных веществ и компонентов — речной или морской воды, тканей живых организмов, растений. Отличаются сложным составом, который не во всех случаях можно точно определить. Сюда относятся бульоны, солодовое сусло, обезжиренное и гидролизованное молоко, овощные отвары, а также кровь и желчь.
Синтетические
Синтетические среды — это субстраты с максимально точным содержанием необходимых химических веществ. Их состав строго рассчитан, а значит полностью известен. Применяются для культивирования и изучения конкретных микроорганизмов — исследования их метаболизма, базовых свойств, способностей принимать вещества, которые подавляют или стимулируют развитие.
Также существуют полусинтетические микробиологические среды. Их основа выполнена из натуральных субстратов, но в состав вводят специальные вещества, обеспечивающие активное размножение культур. Такие субстраты чаще всего применяются в фармацевтике для получения аминокислот, антибиотиков и витаминов.
Рассмотрим также несколько видов субстратов в зависимости от назначения.

Дифференциально-диагностические
Дифференциально-диагностические среды необходимы для отделения разных видов микроорганизмов друг от друга с учётом их ферментативной активности или культуральных проявлений. Состав субстратов рассчитывается таким образом, чтобы было проще выявить свойства каждого вида микроорганизмов, опираясь на особенности обмена веществ. Сюда относятся среды Эндо, Левина, Плоскирева, Гисса и пр. Дополнительно составы могут подкрашивать химическими красителями для идентификации, чтобы было удобнее разделять близкие культуры.
Элективные
Эти среды применяются для отбора и селективного (выборочного) выращивания биологических культур с определёнными качествами. Их состав подбирается таким образом, чтобы подавлять развитие бактерий других видов, но быть оптимальным для требуемой группы (вида) бактерий. Способы создания условий — регулировка кислотности, концентрации солей, питательных веществ. Либо добавление веществ, препятствующих развитию других микроорганизмов. К элективным относятся селенитовые, желчный бульон, щелочной агар, висмут-сульфит агар и пр.
Также существуют среды основные, специальные, консервирующие (транспортировочные), накопления.
Твердые, полужидкие и жидкие
По агрегатному состоянию все составы делятся на три типа. Основой любого субстрата является жидкая среда. Другая консистенция достигается добавлением веществ, повышающих плотность — желатина или агар-агара.
- Жидкие питательные среды используют для накопления микроорганизмов и продуктов их метаболизма, а также для выявления их особенностей. Хранятся такие составы в ёмкостях с плотно завинчивающимися крышками или пробками.
- К полужидким относятся субстраты, в составе которых от 0,2 до 0,7% агара. Чаще всего применяются для хранения культур.
- У твёрдых в составе около 1,5-2,5 % агара. Такие питательные среды используют для выделения бактерий, изучения колоний, учёта количества, определения активности и свойств.
Также существуют сухие субстраты. Это высушенные и измельчённые в порошок вещества (или их комбинации), которые перед применением разводят и стерилизуют.
Приготовление
Приготовление питательной среды включает несколько этапов, а именно:
- взвешивание — отбор навески компонентов на аналитических весах;
- растворение — для растворения применяется нагретая дистиллированная вода;
- кипячение — для кипячения используется водяная баня;
- установление pH — контролируется с помощью индикаторной бумаги;
- фильтрация — производится через бумажные, матерчатые или ватно-марлевые фильтры (в зависимости от консистенции);
- розлив по ёмкостям — не более, чем на ¾ ёмкости;
- стерилизация — осуществляется различными термическими способами;
- контроль — помещение в термостат на двое суток, затем — установление состава химическим путём или засев специальными культурами для проверки свойств.

Методы стерилизации
Стерилизация микробиологических сред осуществляется термическим способом. Это может быть:
- автоклавирование — стерилизация насыщенным паром под давлением;
- тиндализация — дробное нагревание жидкостей с суточными промежутками;
- пастеризация — однократный постепенный нагрев с последующим быстрым охлаждением.
Чаще всего для стерилизации субстратов применяется автоклавирование. Температура, продолжительность и уровень давления в автоклаве выбирается в зависимости от их состава.
и приглашать на предстоящие выставки и семинары






